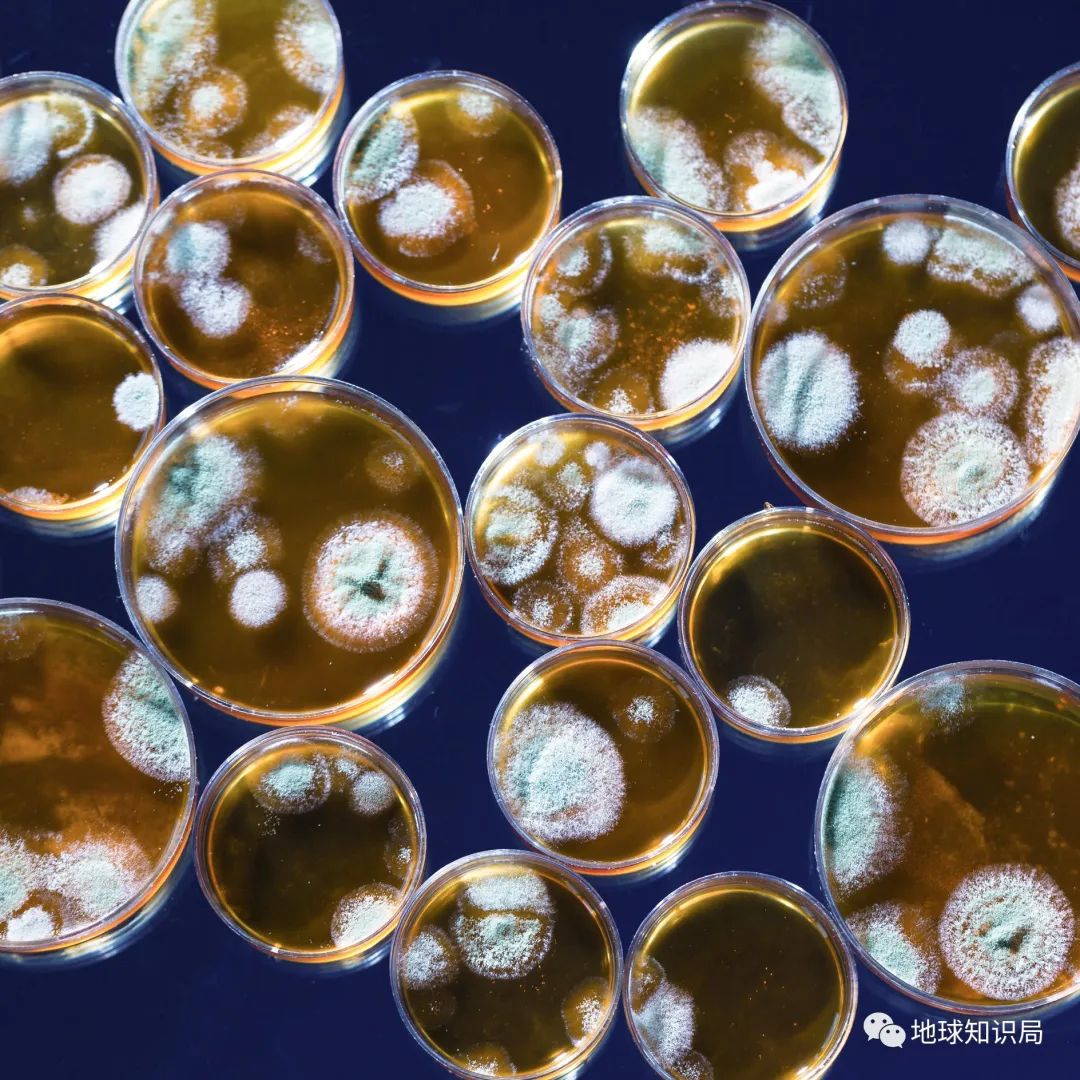

- +1
那个移植猪心脏的美国人,可能死于猪病毒
原创 子昱 地球知识局
 (⊙_⊙)
(⊙_⊙)每天一篇全球人文与地理
微信公众号:地球知识局
异种器官移植
作者:子昱
校稿:辜汉膺 / 编辑:金枪鱼
据外媒报道,美国马里兰大学的研究团队于本月4日表示,全球首例接受猪心脏移植患者在术后两个月死亡,死因或与猪心携带的病毒有关。
研究人员称,他们在这颗猪心脏内发现猪巨细胞病毒DNA,但没有发现这种病毒引起活跃感染迹象,也无法断定病毒是否与患者死因有关联。
今年1月7日,57岁的大卫·贝内特(David Bennett)成功接受了一次特殊的心脏移植手术。为其捐献心脏的,是一头1岁大、重240磅并经过“基因修饰”的猪。
患者当时表示如果可以,依然想移植一个人类心脏
(图:UMMC)▼
 移植过程中(图:马里兰大学医学院)▼
移植过程中(图:马里兰大学医学院)▼ 贝内特术后几周没有任何排异反应,移植的猪心脏表现良好。直到有一天上午醒来后病情恶化,症状类似感染。
贝内特术后几周没有任何排异反应,移植的猪心脏表现良好。直到有一天上午醒来后病情恶化,症状类似感染。医生进行大量检测,试图找出原因,同时对贝内特施以多种抗生素、抗病毒药物以及提高免疫力治疗手段。然而,移植的猪心脏出现肿胀、积液,最终丧失功能,患者于3月8日去世。
移植手术后,贝内特与主刀医生格里芬的合影
可惜贝内特最终还是没能挺过去
(图:UMMC)▼
 虽然人类关于器官移植的梦想古已有之,但直到现代医学完善以后,器官移植手术才能成功实施。可由于人类供体的稀缺,部分学者将目光转向了异种器官移植。
虽然人类关于器官移植的梦想古已有之,但直到现代医学完善以后,器官移植手术才能成功实施。可由于人类供体的稀缺,部分学者将目光转向了异种器官移植。在此之前,异种器官移植仅停留在实验阶段,且大多数异种移植研究都是在非人类灵长类动物身上进行。研究人员希望首例猪-人异种心脏移植手术可以推动科学的进步,并解决目前器官移植所面临的困境。
但异种器官移植的一大风险是,可能导致患者体内出现新感染,而有些“潜伏性”病毒进入人体时没有引发症状而不被察觉。
国际爱猪协会发来强烈谴责(图:壹图网)▼
 合体之梦
合体之梦移植是指将一个生物体的细胞、组织或器官用手术或其他方法,导入自体或另一个个体的某一部分,以替代原已丧失功能的一门技术。
移植手术其实离我们的生活很近
例如——植发(图:图虫)▼
 在古代,不同文化民族的神话传说中都提到了各种各样“半人半兽”的物种,希望人类也能借此获得其他生物的优点,并将这些“半人半兽”赋予神灵的地位。
在古代,不同文化民族的神话传说中都提到了各种各样“半人半兽”的物种,希望人类也能借此获得其他生物的优点,并将这些“半人半兽”赋予神灵的地位。华夏先民们认为人首蛇身的伏羲、女娲是始祖;埃及神话中的神灵有狮身人面、鹰首人身、狼首人身等多种形象;更不用说多种文化里都有提到的“人鱼”形象。
女娲伏羲算是华夏创世神话的顶流CP了
(安能辨我是雌雄?图:壹图网)▼
 显然,“半人半兽”可能永远只能停留在想象中。也因此,当古人因为各种原因造成身体残缺时,首先使用了自然界容易获取的材料。中国先秦时期,就有因战争或受刑罚而缺失四肢后佩戴假肢的记录;在西方中世纪时因罹患梅毒造成鼻子脱落后,使用金属铸造鼻子;《列子·汤问》中甚至记载了扁鹊进行心脏移植手术的故事,但这很有可能只是想象。
显然,“半人半兽”可能永远只能停留在想象中。也因此,当古人因为各种原因造成身体残缺时,首先使用了自然界容易获取的材料。中国先秦时期,就有因战争或受刑罚而缺失四肢后佩戴假肢的记录;在西方中世纪时因罹患梅毒造成鼻子脱落后,使用金属铸造鼻子;《列子·汤问》中甚至记载了扁鹊进行心脏移植手术的故事,但这很有可能只是想象。丹麦天文学家第谷就有一个假鼻子
原来的鼻子和人打架打坏了 (图:壹图网)▼
 关于真正的器官移植,最早有明确记录的是16世纪晚期,意大利外科医生加斯帕尔·塔利亚科齐(Gaspare Tagliacozzi,1545-1599年)开展的皮肤移植手术:把人体一个部位的皮肤移植到另一个部位。
关于真正的器官移植,最早有明确记录的是16世纪晚期,意大利外科医生加斯帕尔·塔利亚科齐(Gaspare Tagliacozzi,1545-1599年)开展的皮肤移植手术:把人体一个部位的皮肤移植到另一个部位。加斯帕尔其中一位做鼻皮肤重建手术的患者
先把手臂和鼻子各切口固定让皮肤长在一起
愈合后再切割分离(图:wiki)▼
 1597年他出版了一本被简译为《生理缺陷移植手术》的插画书,除了详细记录了他的技术外,该书还第一次记载了皮肤移植后的排异反应,他把这种患者自体移植比同种异体移植——即移植物来源于其他人更少出现排斥反应的现象归结为“个性的力量和潜能”。
1597年他出版了一本被简译为《生理缺陷移植手术》的插画书,除了详细记录了他的技术外,该书还第一次记载了皮肤移植后的排异反应,他把这种患者自体移植比同种异体移植——即移植物来源于其他人更少出现排斥反应的现象归结为“个性的力量和潜能”。塔利亚科齐堪称现代医美教父
《生理缺陷移植手术》里的插图真是精彩纷呈
(教父和他写的书)▼

 17世纪,欧洲的医生们尝试将牛羊等动物的血液输入病患体中,期待能治疗他们的“狂暴症”,但大多数患者都当场毙命。由于死亡率太高,后来不得不禁止了这项操作。
17世纪,欧洲的医生们尝试将牛羊等动物的血液输入病患体中,期待能治疗他们的“狂暴症”,但大多数患者都当场毙命。由于死亡率太高,后来不得不禁止了这项操作。比放血疗法还要人命的”输血“疗法
输小牛血,听起来也不打算做人了
(图:ResearchGate)▼
 上世纪一度流行一种叫“鸡血疗法”的保健方法,俗称“打鸡血”。就是把一年生的大公鸡的血,抽出后注射给人体。据说注射了鸡血的人,面色发红,精神亢奋。
上世纪一度流行一种叫“鸡血疗法”的保健方法,俗称“打鸡血”。就是把一年生的大公鸡的血,抽出后注射给人体。据说注射了鸡血的人,面色发红,精神亢奋。雄赳赳,气昂昂,打了鸡血就和斗鸡一样
(图:壹图网)▼
 由于器官移植的难度巨大,需要解决许多问题,长期以来都是禁区。直到19世纪现代外科手术的基石逐渐完善后,外科医生才逐渐开始尝试系统性地器官移植。
由于器官移植的难度巨大,需要解决许多问题,长期以来都是禁区。直到19世纪现代外科手术的基石逐渐完善后,外科医生才逐渐开始尝试系统性地器官移植。器官移植手术面临的困难,除了免疫排斥
还有术后感染的防治(图:图虫创意)▼
 同种器官移植
同种器官移植19世纪,除了较常见的皮肤移植外,眼科医生们开始尝试进行角膜移植。但他们和加斯帕尔遇到了相同的情况:多数人的身体排斥外来组织,将移植物分解并吸收掉了。
此时,横在外科医生们面前的主要是以下两个问题:为什么会产生排异反应?如何维持移植器官的血液供应,或者说是如何保障移植器官所需的氧气和营养?
早期医生认为器官移植最大的困难是血管的重接
所以挑选没有血管的角膜作为实验材料
(最外层透明的就是角膜,图:壹图网)▼
 1902年,法国外科医生亚历克西斯·卡雷尔(Alexis Carrel,1873-1944年)在借鉴了裁缝的经验后,发明了针对血管的“三线缝合法”(三定点端-端吻合术),该技术为血管吻合奠定了基础,并在动物实验中大获成功。
1902年,法国外科医生亚历克西斯·卡雷尔(Alexis Carrel,1873-1944年)在借鉴了裁缝的经验后,发明了针对血管的“三线缝合法”(三定点端-端吻合术),该技术为血管吻合奠定了基础,并在动物实验中大获成功。即使是富有经验的医生,也要数年才能掌握
(看看Q弹爽滑的猪黄喉)▼
 随后几十年中,欧洲的外科医生们开始大胆尝试同种、异种间的器官移植,但大多数患者都因强烈的排异反应,在手术后迅速死亡。
随后几十年中,欧洲的外科医生们开始大胆尝试同种、异种间的器官移植,但大多数患者都因强烈的排异反应,在手术后迅速死亡。二战期间,在研究烧伤后植皮的过程中,英国生物学家彼得·梅达瓦(Peter Brian Medawar,1915-1987年)通过对植皮患者的观察而得出结论:“异体移植物的排斥是由免疫机制引起的”。
彼得·梅达瓦(图:壹图网)▼
 更重要的是,在进行动物实验时,他发现异卵孪生小牛间的皮肤移植并没有排斥,进而发现了“获得性免疫耐受现象”,为解决移植后的排异反应奠定了基础。
更重要的是,在进行动物实验时,他发现异卵孪生小牛间的皮肤移植并没有排斥,进而发现了“获得性免疫耐受现象”,为解决移植后的排异反应奠定了基础。免疫细胞——既是抵御外敌的战士
也是六亲不认的杀手(图:shutterstock)▼
 美国外科医生默瑞于1954年成功地进行了第一例同卵双胞胎之间的肾移植——将健康弟弟的肾脏移植给罹患尿毒症的哥哥。默瑞对病人进行放射线照射,以抑制排斥反应。术后,哥哥的生命延续了八年。
美国外科医生默瑞于1954年成功地进行了第一例同卵双胞胎之间的肾移植——将健康弟弟的肾脏移植给罹患尿毒症的哥哥。默瑞对病人进行放射线照射,以抑制排斥反应。术后,哥哥的生命延续了八年。第一例同卵双胞胎肾移植
(油画藏于哈佛医学院图书馆大厅)▼
 默瑞再接再厉,于1959年又进行了首例活体非亲属供肾的肾脏移植。1962年,他又成功进行了第一例尸体肾脏移植,这次他应用了硫唑嘌呤免疫抑制治疗,使移植肾获得了较长时间的存活。
默瑞再接再厉,于1959年又进行了首例活体非亲属供肾的肾脏移植。1962年,他又成功进行了第一例尸体肾脏移植,这次他应用了硫唑嘌呤免疫抑制治疗,使移植肾获得了较长时间的存活。随后,肝脏移植、心脏移植在美国、南非等地成功实施。在我国,上世纪60年代开始,器官移植手术也在慢慢起步,并逐渐推广,目前多项移植手术均已达到世界先进行列。
青霉素的问世,极大降低了术后感染的风险
是器官移植手术获得长足进步的一个重要原因
(图:图虫创意)▼
异种器官移植
异种器官移植虽然远古时期就有人就幻想过将动物的器官移植给人类,但第一例有明确记录的异种器官移植是在1906年。法国医生杰布雷将一枚猪的肾脏与一名患肾病综合征的48岁妇女的左肘相连,另将一颗羊肾移植给了一名50岁女性,但两人很快因为排异反应死去。
直到去年,猪-人异种肾移植才首次获得成功
相关的研究文献图片还入选了Nature十大年度封面
(图:Nature)▼
 随后几十年,由于同种器官移植的逐渐成熟,加之异种器官移植存在的伦理问题,多数人不再进行该方面的研究、尝试。但随着器官移植的需求量与日俱增,供体也就越来越稀缺。
随后几十年,由于同种器官移植的逐渐成熟,加之异种器官移植存在的伦理问题,多数人不再进行该方面的研究、尝试。但随着器官移植的需求量与日俱增,供体也就越来越稀缺。在这种背景下,异种器官移植再次被提上日程。
为了寻找合适的供体,科学家们首先想到了灵长类动物。1992年,美籍华裔冯宙麟博士成功主刀把一枚狒狒的肝移植到人身上,因为抗体病变,虽然病人只存活了一个月,但却开创了这一领域的奇迹和先河。
狒狒:轮到我开始倒霉了是吗?(图:壹图网)▼
 然而,要么由于体型差异巨大,要么由于亲缘关系太近,其它灵长类动物携带的病毒通常也能感染人类。最终,人们将目光锁定在了猪的身上。这不仅由于猪的器官尺寸与人类相近,更由于数千年的驯化,猪早已具备易繁殖、易饲养等诸多优点。
然而,要么由于体型差异巨大,要么由于亲缘关系太近,其它灵长类动物携带的病毒通常也能感染人类。最终,人们将目光锁定在了猪的身上。这不仅由于猪的器官尺寸与人类相近,更由于数千年的驯化,猪早已具备易繁殖、易饲养等诸多优点。有证据显示,导致艾滋病的人免疫缺陷病毒(HIV)就来源于猴免疫缺陷病毒(SIV)。当然,这种病毒如何从其它灵长类动物来到人的体内,目前不得而知(图:壹图网)▼
 且在经过基因编辑后,这些转基因的“医用猪”体内的器官与人体的相容性大大增强。目前,猪作为供体已在心脏瓣膜置换术中应用了十余年。
且在经过基因编辑后,这些转基因的“医用猪”体内的器官与人体的相容性大大增强。目前,猪作为供体已在心脏瓣膜置换术中应用了十余年。随着新技术的提升,人们有望最大限度地降低猪器官的免疫原性,其它使用猪的器官作为供体的治疗方案也在逐渐走向临床。更多的患者也将得到及时的治疗。与此同时,我们也不应忘记那些为了人类健康而牺牲的小动物们。
谨以此图纪念为人类医学做出牺牲的实验动物们
R.I.P(滑动查看,图:壹图网)▼
 小鼠
小鼠 蟾蜍
蟾蜍 家兔
家兔 比格
比格20世纪60年代末,随着“脑死亡”定义的推广,并进入许多国家的立法层面,器官摘除的法律与伦理困境得以破冰;器官保存液的研制改进让器官在体外保存的时间延长,再加上超音速客机跨洲飞行的便利,以及国际间网络配对捐受双方的高效率,都保证了送往手术台的供体器官最大限度地保持活性。
国内器官配对平台登记志愿者人数已有40多万
小编的朋友也是其中的一份子
但面对浩大的器官受体缺口仍远远不够
(来源:中国人体器官捐献管理中心)▼
 时至今日,同种器官移植仍面临着挑战,其中最大的困境就是供体的稀缺。中国每年仍有约30万患者因器官功能衰竭等待着器官移植,但每年器官移植手术仅有1万余例。
时至今日,同种器官移植仍面临着挑战,其中最大的困境就是供体的稀缺。中国每年仍有约30万患者因器官功能衰竭等待着器官移植,但每年器官移植手术仅有1万余例。此外,对于需要接受眼角膜移植手术的患者而言,由于供体缺少,每年仅有5000例患者可获得移植,仅占需要移植总量的10%。由于供体紧缺,一部分患者耽误了最佳治疗时机,眼球被迫摘除。
在不久的未来
这一困境或许能随着异种器官移植技术的发展被打破
(图:壹图网)▼
 虽然目前异种器官移植手术在技术层面已经可以实现,但在生物学尤其是病毒学领域中还有太多尚待探索的谜题。异种器官移植手术固然可以给广大患者带去福音,但是由病毒等未知因素带来的不确定性风险,还有待医学家们进一步克服。
虽然目前异种器官移植手术在技术层面已经可以实现,但在生物学尤其是病毒学领域中还有太多尚待探索的谜题。异种器官移植手术固然可以给广大患者带去福音,但是由病毒等未知因素带来的不确定性风险,还有待医学家们进一步克服。参考文献:
1. https://www.medschool.umaryland.edu/
2. 全球首例,把猪心移植给患者,终于做到了,来源:澎湃新闻·澎湃号 医学界,2022-01-12 16:05.
3. D K C Cooper, R Gaston, D Eckhoff Et al. Xenotransplantation-the current status and prospects. Br Med Bull. 2018 Mar 1;125(1):5-14. doi: 10.1093/bmb/ldx043.
4. 汤波. 异种器官移植:从过去到未来. 科学24小时. 2019. (12).
5. 中国器官捐献率6年增百倍 器官移植供体仍紧缺,京华时报,2015-09-15 08:32
*本文内容为作者提供,不代表地球知识局立场
封面:shutterstock
END
 原标题:《那个移植猪心脏的美国人,可能死于猪病毒》
原标题:《那个移植猪心脏的美国人,可能死于猪病毒》本文为澎湃号作者或机构在澎湃新闻上传并发布,仅代表该作者或机构观点,不代表澎湃新闻的观点或立场,澎湃新闻仅提供信息发布平台。申请澎湃号请用电脑访问http://renzheng.thepaper.cn。





- 报料热线: 021-962866
- 报料邮箱: news@thepaper.cn
互联网新闻信息服务许可证:31120170006
增值电信业务经营许可证:沪B2-2017116
© 2014-2026 上海东方报业有限公司




